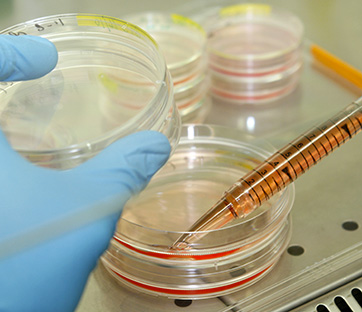

Chi trae vantaggio dalla pubblicità choc sulle staminali
Ricercatori al lavoro su vetrini per la ricerca sulle cellule staminali. Foto: Reuters/Gareth Watkins
In una zona universitaria mi imbatto di recente in un grande cartellone pubblicitario con un messaggio che, unito a una forte immagine “pulp”, non può non colpire la mia attenzione.
Sta scritto a caratteri cubitali: “Big pharma switch off the life. Sosteniamo le cure con cellule staminali contro gli interessi farmaceutici”. L’immagine è quella di una giovane donna dal volto tirato che porge un cuore grondante sangue, trafitto dal simbolo che indica la farmacia.
Torno a casa e sul sito internet richiamato dal cartellone pubblicitario, scopro che la ragazza dell’immagine è una soubrette padovana che ha già fatto dimostrazioni tipo “Femen” per difendere la cura Stamina.
Ora, se una buona pubblicità è quella che colpisce, non c’è dubbio che l’obiettivo sia stato raggiunto. Se questo però possa giovare alla causa risulta più incerto.
Il riferimento a Big Pharma suscita certamente una qualche approvazione nell’immaginario collettivo, a fronte dei molti guai ad essa attribuiti (e ben rappresentati ad esempio dal film denuncia The Constant Gardener - La cospirazione), ma il richiamo alle cure con cellule staminali crea confusione.
Sembrerebbe infatti che tutta l’industria farmaceutica stia sabotando la ricerca sulle cure attraverso l’uso delle cellule staminali, il che non è vero. È di pochi giorni fa la notizia, apparsa sulla rivista Nature, di un esperimento condotto in laboratorio – e riuscito – della ricostruzione del fegato di un topo partendo dalla riprogrammazione di cellule staminali adulte dell’uomo.
Se il bersaglio non sono allora le ricerche sulle staminali, ma la mancata approvazione del metodo Stamina, a entrare in gioco sono le emozioni suscitate da una patologia che colpisce soprattutto i bambini. Ma la salute è un bene troppo serio per diventare terreno di speculazione. E proprio perché la medicina è una disciplina chiamata a misurarsi continuamente con la fragilità dell’uomo – un’arte del possibile alla ricerca continua di nuove soluzioni – essa non può prescindere dall’evidenza scientifica, attraverso la verifica di una metodologia rigorosa e la pubblicità dei dati.
L’effetto dei messaggi pubblicitari in campo sanitario tende spesso ad accreditare l’idea che ad ogni patologia ci possa essere rimedio, creando così la disponibilità a mettersi nelle mani di chiunque prometta il miracolo e ciò va a tutto favore di Big Pharma. Anche in questo giornale è stato infatti ricordato che per certe patologie l’industria farmaceutica ha maggior interesse alla loro cronicizzazione (uguale più farmaci venduti e più profitti) che non ad investire per la loro scomparsa.
Tuttavia la battaglia più efficace contro questi “peccati originali” e contro ogni teoria del complotto sta nel rivendicare maggiore trasparenza nelle ricerche e l’obbligatorietà di libero accesso ai dati grezzi delle sperimentazioni. Significativa a tale proposito è l’iniziativa recentemente adottata da due prestigiose riviste mediche: Plos Medicine e BMJ per l’applicazione dell’Open Data (vedi il loro appello per il RIAT Restoring Invisible and Abandoned Trials).
Per evitare che l’enfatizzazione di informazioni medico-sanitarie produca una frattura tra aspettative della popolazione e risultati terapeutici possibili, è forse il caso di ricordare il decalogo composto ancora nel 1999 da Richard Smith, un medico che oggi si occupa di coordinare i programmi contro la cronicizzazione delle malattie per conto di un gruppo sanitario statunitense (e già direttore per venticinque anni del British Medical Journal). Smith ricorda:
- La morte è inevitabile
- La maggior parte delle malattie gravi non può essere guarita
- Gli antibiotici non servono per curare l’influenza
- Le protesi artificiali ogni tanto si rompono
- Gli ospedali sono luoghi pericolosi
- Tutti i farmaci hanno effetti secondari
- La maggioranza dei trattamenti produce solo benefici marginali e molti non funzionano affatto
- Gli screening producono anche risultati falsi (sia positivi, sia negativi)
- Oltre che acquistare indiscriminatamente tecnologie sanitarie, esistono altri modi per investire le risorse economiche
Un decalogo utile soprattutto per coloro che pretenderebbero una medicina onnipotente, perché non sanno rassegnarsi alla limitatezza di noi umani.
Luciano Rubini









